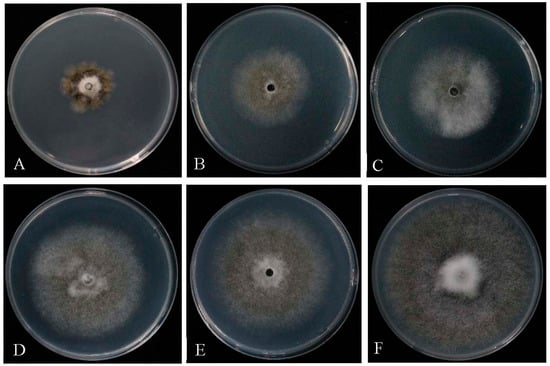

Abstract
Brown rot caused by the pathogen of the genus Monilinia is the most destructive disease in peaches worldwide. It has seriously reduced the economic value of the peach (Prunus persica (L.) Batsch) in Nyingchi and Qamdo, Tibet, China. Monilinia fructicola, Monilia mumecola, and M. yunnanensis have been reported as the causal agents of brown rot disease on stone fruits in China. In this study, we report on the identification of M. yunnanensis in peach orchards in Nyingchi and Qamdo, Tibet. From twenty-three isolates with the same characteristics, we identified the representative single-spore isolates T8-1, T8-8, and T8-20 as M. yunnanensis and confirmed that the Tibet brown rot disease was caused by M. yunnanensis based on the morphological characteristics and molecular analyses. The phylogenetic analysis of the glyceraldehyde-3-phosphate dehydrogenase (G3PDH) and β-tubulin (TUB2) nucleotide sequences and the multiplex PCR identification revealed that the representative isolates T8-1, T8-8, and T8-20 were more closely related to M. yunnanensis than other Monilinia species. Furthermore, the biocontrol strain of Trichoderma T6 presented significant antagonistic activity on the M. yunnanensis T8-1 isolate (T8-1) among the five Trichoderma strains. The highest inhibitory rates for Trichoderma T6 and its fermentation product against T8-1 mycelial growth were 72.13% and 68.25%, respectively. The obvious inhibition zone displayed on the colony interaction area between the colony of T8-1 isolate and Trichoderma T6 and the morphological characterization of the T8-1 hyphae were enlarged and malformed after inoculation with the Trichoderma T6 fermentation product at 20-fold dilution. Our results indicate that the strain of Trichoderma T6 could be considered as a beneficial biocontrol agent in managing brown rot of peach fruit disease.
1. Introduction
Peach (Prunus persica (L.) Batsch) is one of the most important global tree crops within the economically important Rosaceae family, and an important deciduous fruit tree used for worldwide cultivation in temperate and subtropical zones [1]. According to the Food and Agriculture Organization’s statistics, peach trees produce more than 24 million metric tons of fruit per year [2]. China is the largest peach-producing country in the world, with 15.02 million tons of fruit annually in 2020, followed by Spain (1.31 million tons), Italy (1.02 million tons), Turkey and Greece (0.89 million tons each), Iran (0.66 million tons), and the USA (0.56 million tons) [3]. However, peach production is negatively influenced by pre-harvest and post-harvest diseases during the growth, storage, and subsequent shelf-life stages [4]. The brown rot caused by Monilinia spp. represents one of the most economically important and destructive diseases in peach fruit worldwide [5].
Peach brown rot usually appears as soft brown spots on the fruit in the initial stage, and then produced a greyish powdery mass of conidia on the surfaces of the fruit samples after being infected by Monilinia spp. pre-harvest and post-harvest. The species and distribution of the Monilinia pathogens that cause brown rot on peaches have been reported previously. Monilinia fructicola (G. Winter), M. laxa (Aderhold and Ruhland), and M. fructigena (Honey) are three main species found in peach orchards worldwide [6,7]. Monilinia fructicola is one of the most important causal agents of brown rot of peach fruit [8] and is found in peach orchards in Turkey [9], Brazil [10], South Carolina [11], Georgia [12], Spain [13], Italy [14], Czech Republic [15], Slovenia [16], China [6,17,18], Canada [19], Australia [20], and New Zealand [21], causing significant yield losses and damages in the field and during storage and distribution to market. Obi et al. (2018) reported that more than 50% of the global post-harvest peach losses are due to the brown rot disease [5]. Monilinia laxa is another causal agent of brown rot in peach orchards in Turkey [9], Italy [22], and Spain [23,24], whereas M. fructigena is found and detected in peach orchards in Italy [22]. In China, M. fructicola, Monilia mumecola, and M. yunnanensis are the main agents of brown rot [25]. In 2017–2018, approximately 40% of peaches were affected annually by the brown rot disease in peach orchards in Nyingchi and Qamdo, Tibet. The brown rot disease has now become one of the main factors that restricts the yield and quality of peach fruit production and has caused severe economic losses in Tibet due to the changed climate and ineffective management strategies. Therefore, it is urgent to identify the pathogen that causes brown rot in peaches in Tibet and to find effective biocontrol agents to control peach fruit diseases.
Sequence and phylogenetic analyses of the internal transcribed spacer (ITS) region have been widely applied and performed in terms of the taxonomy and molecular phylogeny [26]. For example, they were used for the identification of Monilinia species on the fruit of Crataegus spp. and Rhododendron spp. hosts [27,28]. The phylogenies of TUB2 and G3PDH sequences have also revealed significant taxonomic relations in fungi [29,30,31]. In addition, a new multiplex PCR method was developed to facilitate the detection of M. yunnanensis and the differentiation of Monilinia spp. causing brown rot in peaches in China [25]. However, little is known about the specific species that cause the brown rot disease of peaches in Nyingchi and Qamdo, Tibet.
Trichoderma spp. are well-known beneficial isolates for the antagonistic abilities against many plant pathogens due to their mycoparasitic, reproductive, and competitive capacity [32,33]. Some previous studies have demonstrated that the species of Trichoderma exhibited a wide range of antagonistic abilities against plant pathogens, including Fusarium oxysporum [34,35,36], Alternaria porri [37], Verticillium dahliae [38], Rhizoctonia solani [39], Botrytis cinerea [40,41], Fusarium solani RC 386 [42], Colletotrichum capsici, and M. fructicola [43]. In addition, the fungi of Epicoccum nigrum [44], Penicillium frequentans [45], Candida pruni sp. nov. [46], and Trichothecium roseum [47] have been identified as biocontrol agents in controlling the brown rot disease of stone fruits. However, there is little information regarding the efficacy of Trichoderma spp. against the pathogen of peach brown rot disease in Tibet. The aims of our present study are to (i) survey and describe the Monilinia species infecting the peaches in the primary fruit production regions of Tibet; (ii) carry out a morphological investigation and molecular analysis for the identification of Monilinia species; and (iii) determine the biocontrol activity of Trichoderma strains and their fermentation products against the pathogens isolate in vitro. Our findings would provide a solid basis for making scientific and effective management strategies for the brown rot disease of peach fruit.
2. Material and Methods
2.1. Sample Collection and Pathogen Isolation
Peach (Prunus persica (L.) Batsch) fruit samples were collected from 11 peach orchards in the Nyingchi and Qamdo regions, Tibet. Five trees per peach orchard were investigated, and a total of 23 peach fruit samples with symptoms of brown lesions covered by grayish brown sporodochia were used to isolate the pathogens. Nyingchi is in the southeast of Tibet, at the longitude of 94.362348 E and latitude of 29.654693 N. The average altitude, temperature, and precipitation are about 3000 m, 8–10 °C, and 600–1000 mm, respectively. Qamdo is seated in the eastern part of the Tibet autonomous region, southwest China, at the longitude of 97.1699 E and latitude of 31.145 N. The average altitude, temperature, and precipitation were about 3500 m, 7–8 °C, and 400–600 mm, respectively. The amount of rotten fruit with characteristic sporulation of the pathogen was recorded at harvest by determining the incidence of peach brown rot [48]. The average disease incidence was more than 40% in 2017–2018.
For the identification of Monilinia spp., five small fruit sections (0.5 cm × 0.5 cm) with brown rot symptoms from 23 fruit samples were superficially disinfected with 75% ethanol for 1 min and then with 1% sodium hypochlorite (NaClO) for 1 min, followed by rinsing in sterile distilled water three times. The sterilized fruit sections were dried on sterile paper and placed individually in Petri dishes containing potato dextrose agar (PDA), then the dishes were incubated at 22 °C for 5 days.
2.2. Purification of Isolates
For each isolate, a piece of agar (5 mm in diameter) with mycelia was cut from the edge of a 5-day-old colony and placed upside down onto the center of a fresh PDA medium, then the medium incubated at 22 °C in darkness. Twenty-three isolates were examined morphologically according to Lane (2002) [49]. The isolates with different morphological characteristics were inoculated into peach fruit samples and used as the representative subsamples of single spore isolates for further morphological and molecular characterizations to identify the species. The single-spore isolation process was conducted as described previously by Luo et al. (2002) [50].
2.3. Morphological Observations of Colonies and Conidial Spores
The morphological characteristics (shape, color, stromata) of re-isolated single spores of 23 isolates were observed after inoculation on PDA media. The colony diameter was measured in two perpendicular directions with six replicates. The growth of the obtained colonies on PDA media was recorded, and the average daily growth rate was calculated. The conidia were collected from the lesions developed on peach fruit samples with a gray powdery mass of conidia. The morphological characteristics of the conidia and the conidial germination pattern were observed under a light microscope (E200, Beijing, China). Additionally, the sizes (width and length) of 50 conidia samples were measured for each of the 6 replicates, and the mean value was determined for each isolate.
2.4. Pathogenicity Testing of Isolates
The pathogenicity was tested on the detached and healthy peach fruit samples by inoculating a mycelial plug of the isolates on the surfaces of disinfected mature peach fruit samples. Briefly, healthy peach fruit samples were superficially disinfected with 75% ethanol for 1 min, then rinsed with sterile water three times and air-dried at 22 ± 2 °C prior to inoculation. A 5-mm-diameter plug with active mycelium from a 5-day-old culture of the isolate was inoculated into a 5-mm-diameter wound of a healthy peach. Thereafter, the inoculated fruit samples were placed on a metal support in a plastic container (28.50 cm × 18.5 cm × 9 cm) with sterile water at the bottom. The plastic container was then covered with cling film and incubated at 22 °C with a 12 h/12 h light/dark cycle. The pathogenicity was determined from 2 to 6 days after the inoculation for 1 day internally. At day 6, the infected fruit sample was re-isolated and used to identify the isolates using morphological and molecular characteristics [25]. The healthy peach fruit inoculated with a sterile plug without a mycelium served as the control. All experiments were repeated twice, and three inoculated and control fruit samples were used in one replicate for the treatment and control, respectively.
2.5. Molecular Identification of Representative Isolates
To confirm the morphological identification, genomic DNA samples of the mycelia of pure isolates with the typical brown rot symptoms were extracted using the modified CTAB method. The internal transcribed spacer (ITS) regions 1 and 2, glyceraldehyde-3-phosphate dehydrogenase (G3PDH), and β-tubulin (TUB2) gene fragments were amplified via PCR using the primers ITS1/ITS14, Mon-G3pdhF/Mon-G3pdhR, and Mon-TubF1/Mon-TubR1 of Hu et al. (2011) [25]. The PCR reaction was carried out with a T100™ Thermal Cycler (Bio-Rad, California, USA). The PCR products of the ITS region, G3PDH, and TUB2 genes fragments were sent to Sangon Biotech (Shanghai, Co., Ltd., China) for sequencing. The sequences of the G3PDH and TUB2 genes were aligned using DNAman version 8.0 and used to construct the phylogenetic trees with the neighbor-joining (NJ) method using MEGA version 10.0 with default parameters and 1000 bootstrapping replicates. In addition, a multiplex PCR protocol and reaction were used to identify the representative isolates, which was developed previously to identify the three Monilia species on peaches in China [25].
2.6. Biocontrol Activity of Trichoderma Strains against the Pathogen of T8-1
2.6.1. Trichoderma Strain Preparation and Antagonistic Activity Determination
Five strains of Trichoderma (T6, B3, D5, D6, and J1) were isolated from the soil in Gansu, China, and used in the present study to determine its antifungal potential against the pathogen of the T8-1 isolate in in vitro experiments. The active colony was then prepared via culturing on PDA in Petri dishes for 6 days at 25 °C. The antagonistic activity of the Trichoderma strains against the pathogen T8-1 was assessed following the dual culture plate technique. Each experiment involved six replications. The dishes were incubated at 25 °C for 6 days with supplemental day/night lighting of 16/8 h. The inhibitory rate was calculated according to the formula described by Etebarian et al. (2005) [51] at 6 days after inoculation.
Inhibitory rate (%) = ((Colony radius in control group − Colony radius in treatment group)/(Colony radius in control group − 0.25)) ×100%
2.6.2. Trichoderma Strain Fermentation and Antagonistic Activity Determination
The Trichoderma strains were fermented according to the method described by Zhang et al. (2018) [52]. The fermentation filtrates were then diluted to 20-, 40-, 80-, 160-, and 320-fold with sterile water. For the determination of the antagonistic activity levels of the different dilutions of Trichoderma strain fermentations against the pathogen of the T8-1 isolate, a 0.25-cm-radius plug was collected from a 5-day-old mycelial culture of the T8-1 isolate and placed in the center of fresh PDA medium with 2 mL of Trichoderma T6 fermentation (20- to 320-folds). The PDA medium inoculated with equal volumes of sterile water and T8-1 isolate (without Trichoderma T6 fermentation) was used as the control. The dishes were incubated at 25 °C for 7 days with supplemental day/night lighting of 16/8 h. The inhibitory rate was calculated according to the formula described by Etebarian et al. (2005) [51] at 7 days after inoculation. The morphological characterization of T8-1 hyphae was observed using the microscope observation after inoculation with Trichoderma T6 fermentation (20-fold) at 7 days. The entire experiment had six replications.
2.7. Statistical Analysis
The data analyses were performed with SPSS statistics 20.0 and analyzed via a one-way ANOVA. A comparison between the means was performed using Duncan’s multiple range test and the T values of the adjusted degrees of freedom. The differences were considered significant at p < 0.05.
3. Results
3.1. Symptoms of Peach Brown Rot in Fields
Our field investigation found that the fruit infection appeared as soft brown spots that rapidly produced a greyish powdery mass of conidia, often in concentric rings on the rotted areas during the growing period (Figure 1A–C). The infected fruit eventually dried, shriveled into wrinkled mummies and attached to the tree until harvest (Figure 1D,E).

Figure 1.
Symptoms of peach brown rot caused by Monilia yunnanensis in the field in Tibet, China: (A–C) during the growing season; (D,E) at harvest time.
3.2. Isolates Purification
At day 5, 23 pure-culture isolates with the same characteristics were isolated and coded as T8-1 to T8-23 for hyphal tip isolation and further experimentation. The colony colors of the isolates were white to gray-green with even concentric rings and margins. The average daily growth rate of the obtained colonies on the PDA media was 10.52 mm. T8-1, T8-8, and T8-20 were isolated from different years and regions and used to ascertain the pathogen species based on morphological and molecular characteristics.
3.3. Characteristics of Single Spores of the Representative Isolate T8-1
After 13 days of incubation at 22 °C on PDA medium, the T8-1, T8-8, and T8-20 pure-culture isolate colonies had same characteristics. The color of the representative isolate T8-1 colony changed from white to grayish, then the stromata developed (Figure 2A,B) and the color of the colony changed from grayish to brown to black. Abundant black stromata developed after 16 days of incubation (Figure 2C,D). The conidia were hyaline, one-celled, mostly lemon-shaped, and formed branched chains on the inoculated peach fruit samples. The average diameters of the conidia were 11.11 to 19.21 μm (mean = 15.16 μm) × 8.18 to 13.52 μm (mean = 10.85 μm) (Figure 2E,F). Additionally, we found that two germ tubes were often produced from the pointy sides of the conidia (Figure 2G,H).

Figure 2.
Characteristics of a single-spore isolate of Monilia yunnanensis (isolate T8-1) grown on PDA medium at 22 °C for 13 and 16 days: (A,B) front and reverse views of T8-1 colonies at 13 days after inoculation, respectively; (C,D) front and reverse colonies of T8-1 colonies at 16 days after inoculation, respectively; (E,F) the conidial morphology characteristics of T8-1; (G,H) the conidial germ tube morphology characteristics of T8-1.
3.4. Pathogenicity Test on Peach Fruit Samples at Different Days after Inoculation
After 2–3 days of incubation of the inoculated fruit samples with T8-1, T8-8, and T8-20 at 22 °C, the T8-1 isolate had high pathogenicity. The typical brown rot symptoms appeared (Figure 3A) and the size of the rot area increased as the incubation time increased with the representative isolate T8-1 (Figure 3B). Thereafter, the fruit infections appeared as soft brown spots that rapidly produced white hyphae at day 4 (Figure 3C), and then at day 5 a greyish powdery mass of conidia formed in the concentric rings on the rotted areas (Figure 3D). At day 6, all inoculated fruit samples developed brown rot symptoms that were similar to those observed in the fields (Figure 3E), while no symptoms were observed on the control fruit samples (Figure 3F).

Figure 3.
Symptoms from the pathogenicity tests on peach fruit samples at different days after inoculation with the isolate T8-1: (A–E) the symptoms at 2, 3, 4, 5, and 6 days after inoculation with the T8-1 isolate; (F) the control peach at 6 days after inoculation with sterile PDA plugs without the T8-1 isolate (control).
3.5. Molecular Identification of Representative Isolates
The consensus sequence of the ITS regions of the T8-1, T8-8, and T8-20 isolates were 99.40 to 99.79% and 98.58 to 98.79% identical to those of M. fructicola (accession no. KF516935) and M. yunnanensis (accession no. MW355895), respectively. The sequences of the T8-1, T8-8, and T8-20 TUB2 and G3PDH genes had higher identity rates of 99.00 to 99.93% and 98.48 to 99.86% to the TUB2 and G3PDH sequences of M. yunnanensis (accession no. HQ908773 and HQ908782), respectively, than those of other Monilinia species, and formed a monophyletic clade with those of M. yunnanensis (HQ908783 and HQ908782) in the TUB2 and G3PDH phylogenetic trees, with bootstrapping support values of 0.01 and 0.005, respectively (Figure 4A,B). The results of the multiplex PCR detection test showed that a 354 bp fragment was amplified from the T8-1, T8-8, and T8-20 isolates, indicating that the T8-1, T8-8, and T8-20 isolates were from the Monilia genus. Additionally, a fragment of 237 bp was amplified from the T8-1, T8-8, and T8-20 isolates, which indicated them as M. yunnanenis (Figure 5). From the results of the multiplex PCR detection and ITS region tests, and the TUB2 and G3PDH genes sequencing confirmed that the T8-1, T8-8, and T8-20 isolates were from M. yunnanensi.


Figure 4.
Phylogenetic trees of the representative isolates T8-1, T8-8, and T8-20 were inferred from sequences of TUB2 (A) and G3PDH (B). The photogenic trees were formed with the neighbor-joining (NJ) method using MEGA version 10.

Figure 5.
Multiplex polymerase chain reaction (PCR) results for the representative isolates T8-1, T8-8, and T8-20. Lane M, marker.
3.6. Biocontrol Activity of Trichoderma Strains against the Pathogen of the M. yunnanenis T8-1 Isolate
Compared to the control (Figure 6K), different strains of Trichoderma exhibited the significant antagonistic activity on the pathogen of M. yunnanenis T8-1 isolate (T8-1). The colony radius of the T8-1 isolate was significantly inhibited at 6 days after inoculation with the Trichoderma strains T6 (Figure 6A), B3 (Figure 6C), D5 (Figure 6E), J1 (Figure 6G), and D6 (Figure 6I). The colony interaction area showed an obvious inhibition zone between the colonies of the Trichoderma strains T6 (Figure 6B), B3 (Figure 6D), D5 (Figure 6F), J1 (Figure 6H), and D6 (Figure 6J) and the T8-1 isolate, respectively. The T8-1 isolate colony color changed to brown in comparison to the control. The inhibitory rates of the T8-1 isolate were 72.13%, 63.67%, 62.57%, 64.48%, and 61.75% at 6 days after inoculation with the Trichoderma strains T6, B3, D5, J1, and D6, respectively (Table 1). The Trichoderma strain T6 had a significant inhibitory effect on the T8-1 isolate in comparison to the other four strains (Table 1).

Figure 6.
Antagonistic activity levels of five Trichoderma strains against Monilia yunnanensis after dual culture at 6 days: (A,C,E,G,I) the antagonistic activity levels of Trichoderma strains T6, B3, D5, J1, and D6 against M. yunnanensis in dual culture, respectively; (B,D,F,H,J) the interactions of Trichoderma T6, B3, D5, J1, and D6 colonies with M. yunnanensis, respectively; (K) the normal colony of M. yunnanensis (control).

Table 1.
Inhibitory activity of Trichoderma strains on the growth of the peach brown rot pathogen of the Monilia yunnanensis T8-1 isolate.
3.7. Biocontrol Activity and Morphological Characterization of Trichoderma T6 Fermentation against the Pathogen of the M. yunnanenis T8-1 Isolate
Different dilutions of the Trichoderma T6 fermentation exhibited significant antagonistic activity on the pathogen of the M. yunnanenis T8-1 isolate. The inhibitory rates of the T8-1 isolate were increased with decreasing Trichoderma T6 fermentation dilutions. The colony radius of the T8-1 isolate was significantly inhibited at 7 days after being inoculated with 20- (Figure 7A), 40- (Figure 7B), 80- (Figure 7C), 160- (Figure 7D), and 320-fold (Figure 7E) Trichoderma T6 fermentation dilutions in comparison to the control (Figure 7F). The inhibitory rates of the T8-1 isolate were 68.25%, 50.00%, 41.00%, 27.00%, and 18.00% at 7 days after inoculation with 20-, 40-, 80-, 160-, and 320-fold Trichoderma T6 fermentation dilutions, respectively (Table 2). In addition, the morphological characterization of the T8-1 isolate hyphae was enlarged and malformed after inoculation with the Trichoderma T6 fermentation product (20-fold dilution) (Figure 8A) at 7 days, whereas the normal hyphae of the T8-1 isolate were observed in the control group (Figure 8B).
Figure 7.
Antagonistic activity levels of Trichoderma T6 fermentation against Monilia yunnanensis after inoculation at 7 days: (A–F) the antagonistic activity levels of 20-, 40-, 80-, 160-, and 320-fold fermentation dilutions and the sterile water (control), respectively.

Table 2.
Inhibitory activity levels of Trichoderma T6 fermentation products on the growth of the Monilia yunnanensis T8-1 isolate.

Figure 8.
Morphological characterization of Monilia yunnanensis hyphae after inoculation with Trichoderma T6 fermentation (20-fold) at 7 days: (A) the hyphae of M. yunnanensis was enlarged and malformed after inoculation with Trichoderma T6 fermentation; (B) the normal hyphae of M. yunnanensis in the control group after inoculation with sterile water (Control). The arrow represents the enlarged and malformed hyphae.
4. Discussion
Our present study reports the first record of a Monilia species causing brown rot in peaches in the Nyingchi and Qamdo regions, Tibet. Based on the morphological characterization and molecular identification, the representative isolates of T8-1, T8-8, and T8-20 were identified as M. yunnanensis. Meanwhile, we reported that M. yunnanensis can cause brown rot in nectarines in Nyingchi, Tibet [53]. However, there is no information regarding the Monilia species causing brown rot in peaches in the Nyingchi and Qamdo regions. To our knowledge, this is the first report of M. yunnanensis causing brown rot in peaches in Nyingchi and Qamdo, Tibet.
The morphological characteristics in terms of the spore size, colony morphology, growth rate, and pathogenicity of the isolates T8-1, T8-8, and T8-20 on the peach fruit samples are very similar to those of M. yunnanensis. Monilia yunnanensis was first reported as a new fungal species causing peach brown rot in Yunnan province, China [25]. Since then, it has been reported as the pathogenic agent of brown rot on hawthorn [54], plum [55], and apricot [56] samples in China.
The biological-morphology-based species identification results were subsequently confirmed by the multiplex PCR method, showing the T8-1, T8-8, and T8-20 isolates as M. yunnanenis. Furthermore, the phylogenetic analysis of the ITS sequences indicated that the isolates T8-1, T8-8, and T8-20 are most closely related to M. fructicola and M. yunnanensis, whereas the G3PDH and TUB2 sequences are most closely related to M. yunnanensis. However, the morphological characteristics are significantly different between M. fructicola and M. yunnanensis. The colonies of M. fructicola from peach and plum samples are brown with fluffy mycelia and abundant mycelial tufts of sporulation [6,54]. In contrast, the colony of M. yunnanensis is gray-greenish and covered with whitish felty mycelia and minor exceptions of lobbed margins. Monilia yunnanensis also has no mycelial tufts of sporulation [25,55,56]. Therefore, the representative isolates of T8-1, T8-8, and T8-20 were identified as M. yunnanensis based on both their morphological and molecular characteristics.
Furthermore, our results showed that the strain of Trichoderma T6 and its fermentation presented significant antagonistic activity on the pathogen of the M. yunnanenis T8-1 isolate (T8-1). A previous study reported that T. harzianum ITEM 3636 can inhibit the pathogen of peanut brown root rot (F. solani RC 386) in terms of mycelial growth. The highest inhibition growth percentages for T. harzianum ITEM 3636 and its filtered liquid cultures were 48.4% and 78.2%, respectively [42]. Similarly, the inhibition effects of T. afroharzianum TM24 on B. cinerea, F. oxysporum f. sp. cucumerinum, C. capsici, M. fructicola, and F. oxysporum f. sp. niveum reached 74.2%, 43.4%, 51.9%, 66.7%, and 51.0%, respectively [43]. Our results revealed that the highest inhibitory rates of Trichoderma T6 and its fermentation product against T8-1 isolate mycelial growth were 72.13% and 68.25%, respectively. Fu et al. (2017) reported that the antagonistic activity of the natural compound berberine on M. fructicola was 72.7% at 23.44 µg/mL [57]. The result from our present study shows no significant difference in comparison to the biocontrol agent of berberine. In addition, we found an obvious inhibition zone displayed on the colony interaction area between the colony of the T8-1 isolate and Trichoderma T6, and even the enlarged and malformed hyphae of the T8-1 isolate was observed after inoculation with Trichoderma T6 fermentation.
5. Conclusions
In the present study, we identified M. yunnanensis in peach orchards in the regions of Nyingchi and Qamdo, Tibet. The strain Trichoderma T6 could be considered as a beneficial biocontrol agent in controlling peach brown rot disease. The future research will focus on the biocontrol mechanisms of Trichoderma T6 and its fermentation product against peach brown root rot caused by M. yunnanensis.
Author Contributions
S.Z., C.S., D.X., T.L. and K.H. performed the experiments and analyzed data. S.Z. designed the experiments and wrote and edited the manuscript. B.X. and J.Z. revised the manuscript. All authors have read and agreed to the published version of the manuscript.
Funding
This work was supported by a research program sponsored by the Fuxi Outstanding Talent Cultivation Program, Gansu Agricultural University (Project Gaufx-03J03); the Longyuan Youth Innovation and Entrepreneurship Talent Project (2021LQTD27); the Scientific Research Start-Up Funds for Openly Recruited Doctors (project 2017RCZX-07); and the Program for Introducing Talent to Chinese Universities (111 program no. D20023).
Institutional Review Board Statement
Not applicable.
Informed Consent Statement
Not applicable.
Data Availability Statement
The data in this study are available on request from the corresponding author or first author.
Conflicts of Interest
The authors declare that the research was conducted in the absence of any commercial or financial relationships that could be construed as a potential conflict of interest.
References
- FAOSTAT. Food and Agricultural Organization of the United Nations. 2020. Available online: https://www.statista.com/statistics/264001/worldwide-production-of-fruit-by-variety/ (accessed on 26 January 2020).
- FAOSTAT. Food and Agricultural Organization of the United Nations. 2017. Available online: http://www.fao.org/faostat/en/#data (accessed on 26 January 2020).
- FAOSTAT. Food and Agricultural Organization of the United Nations. 2020. Available online: https://www.fao.org/faostat/en/#data/QCL (accessed on 26 January 2020).
- Sisquella, M.; Viñas, I.; Picouet, P.; Torres, R.; Usall, J. Effect of host and Monilinia spp. variables on the efficacy of radio frequency treatment on peaches. Postharvest Biol. Tec. 2014, 87, 6–12. [Google Scholar] [CrossRef]
- Obi, V.I.; Barriuso, J.J.; Gogorcena, Y. Peach brown rot: Still in search for an ideal management option. Agriculture 2018, 8, 125. [Google Scholar] [CrossRef]
- Hu, M.J.; Chen, Y.; Chen, S.N.; Liu, X.L.; Yin, L.F.; Luo, C.X. First report of brown rot of peach caused by Monilinia fructicola in southeastern China. Plant Dis. 2011, 95, 225. [Google Scholar] [CrossRef]
- Zhu, X.Q.; Zheng, H.H.; Fang, Y.L.; Guo, L.Y. A method to induce significant production of conidia from Monilinia fructigena, Monilia polystroma, and Monilia yunnanensis. Australas. Plant Pathol. 2014, 43, 531–533. [Google Scholar] [CrossRef]
- Zhu, X.Q.; Chen, X.Y.; Luo, Y.; Guo, L.Y. First report of Monilinia fructicola on peach and nectarine in China. Plant Pathol. 2005, 54, 575. [Google Scholar] [CrossRef]
- Ozkilinc, H.; Yildiz, G.; Silan, E.; Arslan, K.; Guven, H.; Altinok, H.H.; Altindag, R.; Durak, M.R. Species diversity, mating type assays and aggressiveness patterns of Monilinia pathogens causing brown rot of peach fruit in Turkey. Eur. J. Plant Pathol. 2020, 157, 799–814. [Google Scholar] [CrossRef]
- Fischer, J.M.M.; Savi, D.C.; Aluizio, R.; De Mio, M.L.L.; Glienke, C. Characterization of Monilinia species associated with brown rot in stone fruit in Brazil. Plant Path. 2017, 66, 423–436. [Google Scholar] [CrossRef]
- Landgraf, F.A.; Zehr, E.I. Inoculum sources for Monilinia fructicola in South Carolina peach orchards. Phytopathology 1982, 72, 185–190. [Google Scholar] [CrossRef]
- Emery, K.M.; Michailides, T.J.; Scherm, H. Incidence of latent infection of immature peach fruit by Monilinia fructicola and relationship to brown rot in Georgia. Plant Dis. 2000, 84, 853–857. [Google Scholar] [CrossRef][Green Version]
- de Cal, A.; Gell, I.; Usall, J.; Viñas, I.; Melgarejo, P. First report of brown rot caused by Monilinia fructicola in peach orchards in Ebro Valley, Spain. Plant Dis. 2009, 93, 763. [Google Scholar] [CrossRef]
- Pellegrino, C.; Gullino, M.L.; Garibaldi, A.; Spadaro, D. First report of brown rot of stone fruit caused by Monilinia fructicola in Italy. Plant Dis. 2009, 93, 668. [Google Scholar] [CrossRef]
- Duchoslavová, J.; Širučková, I.; Zapletalová, E.; Navrátil, M.; Šafářová, D. First report of brown rot caused by Monilinia fructicola on various stone and pome fruits in the Czech Republic. Plant Dis. 2007, 91, 907. [Google Scholar] [CrossRef]
- Munda, A.; Viršček, M.M. First report of brown rot caused by Monilinia fructicola affecting peach orchards in Slovenia. Plant Dis. 2010, 94, 1166. [Google Scholar] [CrossRef]
- Zhong, Y.F.; Zhang, Y.W.; Chen, X.Y.; Luo, Y.; Guo, L.Y. Overwintering of Monilinia fructicola in stone fruit orchards in northern China. J. Phytopathol. 2008, 156, 229–235. [Google Scholar] [CrossRef]
- Yin, L.F.; Chen, G.K.; Chen, S.N.; Du, S.F.; Li, G.Q.; Luo, C.X. First report of brown rot caused by Monilia mumecola on Chinese sour cherry in Chongqing Municipality, China. Plant Dis. 2014, 98, 7. [Google Scholar] [CrossRef]
- Biggs, A.R.; Northover, J. Early and late-season susceptibility of peach fruits to Monilinia fructicola. Plant Dis. 1988, 72, 1070–1074. [Google Scholar] [CrossRef]
- Tran, T.T.; Li, H.; Nguyen, D.Q.; Sivasithamparam, K.; Jones, M.G.K.; Wylie, S.J. Spatial distribution of Monilinia fructicola and M. laxa in stone fruit production areas in Western. Australas. Plant Pathol. 2017, 46, 339. [Google Scholar] [CrossRef]
- Elmer, P.A.G.; Spiers, T.M.; Wood, P.N. Effects of pre-harvest foliar calcium sprays on fruit calcium levels and brown rot of peaches. Crop Prot. 2007, 26, 11–18. [Google Scholar] [CrossRef]
- Abate, D.; Pastore, C.; Gerin, D.; De Miccolis Angelini, R.M.; Rotolo, C.; Pollastro, S.; Faretra, F. Characterization of Monilinia spp. populations on stone fruit in South Italy. Plant Dis. 2018, 102, 1708–1717. [Google Scholar] [CrossRef]
- Gell, I.; Larena, I.; Melgarejo, P. Genetic diversity in Monilinia laxa populations in peach orchards in Spain. J. Phytopathol. 2007, 155, 549–556. [Google Scholar] [CrossRef]
- Gell, I.; De Cal, A.; Torres, R.; Usall, J.; Melgarejo, P. Relationship between the incidence of latent infections caused by Monilinia spp. and the incidence of brown rot of peach fruit: Factors affecting latent infection. Eur. J. Plant Pathol. 2008, 121, 487–498. [Google Scholar] [CrossRef]
- Hu, M.J.; Cox, K.D.; Schnabel, G.; Luo, C.X. Monilinia species causing brown rot of peach in China. PLoS ONE 2011, 6, e24990. [Google Scholar] [CrossRef] [PubMed]
- Iwen, P.C.; Hinrichs, S.H.; Rupp, M.E. Utilization of the internal transcribed spacer regions as molecular targets to detect and identify human fungal pathogens. Med. Mycol. 2002, 40, 87–109. [Google Scholar] [CrossRef] [PubMed]
- Holst-Jensen, A.; Kohn, L.; Jakobsen, K.; Schumacher, T. Molecular phylogeny and evolution of Monilinia (Sclerotiniaceae) based on coding and noncoding rDNA sequences. Am. J. Bot. 1997, 84, 686–701. [Google Scholar] [CrossRef] [PubMed]
- Takahashi, Y.; Ichihashi, Y.; Sano, T.; Harada, Y. Monilinia jezoensis sp. nov. in the Sclerotiniaceae, causing leaf blight and mummy fruit disease of Rhododendron kaempferi in Hokkaido, northern Japan. Mycoscience 2005, 46, 106–109. [Google Scholar] [CrossRef]
- Fournier, E.; Giraud, T.; Albertini, C.; Brygoo, Y. Partition of the Botrytis cinerea complex in France using multiple gene genealogies. Mycologia 2005, 97, 1251–1267. [Google Scholar] [CrossRef]
- O’Gorman, D.T.; Sholberg, P.L.; Stokes, S.C.; Ginns, J. DNA sequence analysis of herbarium specimens facilitates the revival of Botrytis mali, a postharvest pathogen of apple. Mycologia 2008, 100, 227–235. [Google Scholar] [CrossRef]
- Staats, M.; van Baarlen, P.; van Kan, J.A.L. Molecular phylogeny of the plant pathogenic genus Botrytis and the evolution of host specificity. Mol. Biol. Evol. 2005, 22, 333–346. [Google Scholar] [CrossRef]
- Hermosa, R.; Viterbo, A.; Chet, I.; Monte, E. Plant-beneficial effects of Trichoderma and of its genes. Microbiology 2012, 158, 17–25. [Google Scholar] [CrossRef] [PubMed]
- Lopes, F.A.C.; Steindorff, A.S.; Geraldine, A.M.; Brandao, R.S.; Monteiro, V.N.; Júnior, M.L.; Coelho, A.S.G.; Ulhoa, C.J.; Silva, R.N. Biochemical and metabolic profiles of Trichoderma strains isolated from common bean crops in the Brazilian Cerrado, and potential antagonism against Sclerotinia sclerotiorum. Fungal Biol. 2012, 116, 815–824. [Google Scholar] [CrossRef]
- El Komy, M.H.; Saleh, A.A.; Eranthodi, A.; Molan, Y.Y. Characterization of novel Trichoderma asperellum isolates to select effective biocontrol agents against tomato Fusarium wilt. Plant Pathol. J. 2015, 31, 50–60. [Google Scholar] [CrossRef]
- Mwangi, M.W.; Muiru, W.M.; Narla, R.D.; Kimenju, J.W.; Kariuki, G.M. Management of Fusarium oxysporum f. sp. lycopersici and root-knot nematode disease complex in tomato by use of antagonistic fungi, plant resistance and neem. Biocontrol Sci. Technol. 2019, 29, 207–216. [Google Scholar]
- Zhang, F.L.; Liu, C.; Wang, Y.; Dou, K.; Chen, F.; Pang, L.; Kong, X.; Shang, C.; Li, Y. Biological characteristic and biocontrol mechanism of Trichoderma harzianum T-A66 against bitter gourd wilt caused by Fusarium oxysporum. J. Plant Pathol. 2020, 102, 1107–1120. [Google Scholar] [CrossRef]
- Abo-Elyousr, K.A.M.; Abdel-Hafez, S.I.I.; Abdel-Rahim, I.R. Isolation of Trichoderma and evaluation of their antagonistic potential against Alternaria porri. J. Phytopathol. 2014, 162, 567–574. [Google Scholar] [CrossRef]
- Irene, C.C.; José, L.T.C.; Concepción, O.G.; Enrique, M.; Rosa, H.; Rafael, M.J.D. Trichoderma asperellum is effective for biocontrol of Verticillium wilt in olive caused by the defoliating pathotype of Verticillium dahlia. Crop Prot. 2016, 88, 45–52. [Google Scholar]
- Swain, H.; Adak, T.; Mukherjee, A.K.; Mukherjee, P.K.; Bhattacharyya, P.; Behera, S.; Bagchi, T.B.; Patro, R.S.; Khandual, A.; Bag, M.K.; et al. Novel Trichoderma strains isolated from tree barks as potential biocontrol agents and biofertilizers for direct seeded rice. Microbiol. Res. 2018, 214, 83–90. [Google Scholar] [CrossRef] [PubMed]
- You, J.Q.; Zhang, J.; Wu, M.D.; Yang, L.; Chen, W.D.; Li, G.Q. Multiple criteria-based screening of Trichoderma isolates for biological control of Botrytis cinerea on tomato. Biol. Control 2016, 101, 31–38. [Google Scholar] [CrossRef]
- Abbey, J.A.; Percival, D.; Abbey, L.; Asiedu, S.K.; Prithiviraj, B.; Schilder, A. Biofungicides as alternative to synthetic fungicide control of grey mould (Botrytis cinerea)-prospects and challenges. Biocontrol Sci. Technol. 2019, 29, 241–262. [Google Scholar] [CrossRef]
- Erazo, J.G.; Palacios, S.A.; Pastor, N.; Giordano, F.D.; Rovera, M.; Reynoso, M.M.; Venisse, J.S.; Torres, A.M. Biocontrol mechanisms of Trichoderma harzianum ITEM 3636 against peanut brown root rot caused by Fusarium solani RC 386. Biol. Control 2021, 164, 104774. [Google Scholar] [CrossRef]
- Yánez-Mendizábal, V.; Zeriouh, H.; Viñas, I.; Torres, R.; Usall, J.; de Vicente, A.; Pérez-García, A.; Teixidó, N. Biological control of peach brown rot (Monilinia spp.) by Bacillus subtilis CPA-8 is based on production of fengycin-like lipopeptides. Eur. J. Plant Pathol. 2012, 132, 609–619. [Google Scholar] [CrossRef]
- De Cal, A.; Larena, I.; Linan, M.; Torres, R.; Lamarca, N.; Usall, J.M.; Domenichini, P.; Bellini, A.; de Eribe, X.O.; Melgarejo, P. Population dynamics of Epicoccum nigrum, a biocontrol agent against brown rot in stone fruits. J. Appl. Microbiol. 2009, 106, 592–605. [Google Scholar] [CrossRef] [PubMed]
- Guijarro, B.; Melgarejo, P.; De Cal, A. Influence of additives on adhesion of Penicillium frequentans conidia to peach fruit surfaces and relationship to the biocontrol of brown rot caused by Monilinia laxa. Int. J. Food Microbiol. 2008, 126, 24–29. [Google Scholar] [CrossRef] [PubMed]
- Zhang, D.P.; Lu, C.G.; Zhang, T.T.; Spadaro, D.; Liu, D.W.; Liu, W.C. Candida pruni sp. nov. is a new yeast species with antagonistic potential against brown rot of peaches. Arch. Microbiol. 2014, 196, 525–530. [Google Scholar] [CrossRef] [PubMed]
- May-De Mio, L.L.; Negri, G.; Michailides, T.J. Effect of Trichothecium roseum, lime sulphur and phosphites to control blossom blight and brown rot on peach. Can. J. Plant Pathol. 2014, 36, 428–437. [Google Scholar] [CrossRef]
- Keske, C.; Amorimb, L.; May-De Mio, L.L. Peach brown rot incidence related to pathogen infection at different stages of fruit development in an organic peach production system. Crop Prot. 2011, 30, 802–806. [Google Scholar] [CrossRef]
- Lane, C. A synoptic key for differentiation of Monilinia fructicola, M. fructigena and M. laxa, based on examination of cultural characters. EPPO Bull. 2002, 32, 489–493. [Google Scholar] [CrossRef]
- Luo, C.X.; Hanamura, H.; Sezaki, H.; Kusaba, M.; Yaegashi, H. Relationship between avirulence genes of the same family in rice blast fungus Magnaporthe grisea. J. Gen. Plant Pathol. 2002, 68, 300–306. [Google Scholar] [CrossRef]
- Etebarian, H.R.; Sholberg, P.L.; Eastwell, K.C.; Sayler, R.J. Biological control of apple blue mold with Pseudomonas fluorescens. Can. J. Microbiol. 2005, 51, 591–598. [Google Scholar] [CrossRef]
- Zhang, S.W.; Xu, B.L.; Zhang, J.H.; Gan, Y.T. Identification of the antifungal activity of Trichoderma longibrachiatum T6 and assessment of bioactive substances in controlling phytopathgens. Pestic. Biochem. Phys. 2018, 147, 59–66. [Google Scholar] [CrossRef]
- Zhang, S.W.; Xiang, D.; Li, T.; Xu, B.L. First report of brown rot of nectarine caused by Monilia yunnanensis in Tibet. Plant Dis. 2021, 105, 1853. [Google Scholar] [CrossRef]
- Zhao, Y.Z.; Wang, D.; Liu, Z.H. First report of brown rot on Crataegus pinnatifida var. major caused by Monilia yunnanensis in China. Plant Dis. 2013, 97, 1249–1250. [Google Scholar] [CrossRef] [PubMed]
- Yin, L.F.; Chen, S.N.; Chen, G.K.; Schnabel, G.; Du, S.F.; Chen, C.; Li, G.Q.; Luo, C.X. Identification and characterization of three Monilinia species from plum in China. Plant Dis. 2015, 99, 1775–1783. [Google Scholar] [CrossRef] [PubMed][Green Version]
- Yin, L.F.; Cai, M.L.; Du, S.F.; Luo, C.X. Identification of two Monilia species from apricot in China. J. Integr. Agr. 2017, 16, 2496–2503. [Google Scholar] [CrossRef]
- Fu, W.H.; Tian, G.R.; Pei, Q.H.; Ge, X.Z.; Tian, P.F. Evaluation of berberine as a natural compound to inhibit peach brown rot pathogen Monilinia fructicola. Crop Prot. 2017, 91, 20–26. [Google Scholar] [CrossRef]
Publisher’s Note: MDPI stays neutral with regard to jurisdictional claims in published maps and institutional affiliations. |
© 2022 by the authors. Licensee MDPI, Basel, Switzerland. This article is an open access article distributed under the terms and conditions of the Creative Commons Attribution (CC BY) license (https://creativecommons.org/licenses/by/4.0/).